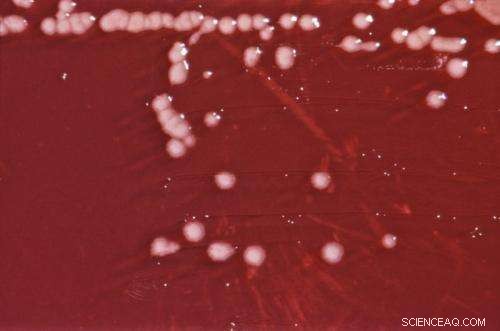
Bacteria Selectively Metabolize Carbon Sources Under Iron-Deficiency

Pseudomonas aeruginosa bacterial culture on an Xylose Lysine Sodium Deoxycholate (XLD) agar plate. Credit: CDC/public domain
When humans have low iron levels, they tend to feel weak, fatigued and dizzy. This fatigue prevents patients with iron-deficient anemia from exercising or exerting themselves in order to conserve energy.
Similarly, in low-iron environments, microbes survive by slowing down carbon processing and extracting iron from minerals. However, this strategy requires microbes to invest precious food sources into producing mineral-dissolving compounds. Given this paradox, researchers wanted to understand how microbes sustain survival strategies in environments with too little iron to thrive.
Iron is critical to carbon metabolism because it's required by the proteins involved in processing carbon. But because oxygen makes soluble iron less abundant in the environment, bacteria often operate under iron limitation and need to shut down or dramatically decrease carbon intake.
Looking at a group of bacteria from soil, researchers at Northwestern University discovered that these organisms overcome limitation in their carbon processing machinery by rerouting their metabolic pathways to favor producing iron-scavenging compounds. The study is the first to use metabolomics, a high-resolution technique to monitor carbon flow in the cells, to study the impact of iron on the carbon cycling in bacterial cells.
The study was published today in the journal Proceedings of the National Academy of Sciences.
Ludmilla Aristilde, an associate professor of civil and environmental engineering at the McCormick School of Engineering, led the research. Her research group focuses on understanding environmental processes that involve organics, with implications for ecosystem health, agricultural productivity and environmental biotechnology.
Within the network of metabolism in bacteria, the citric acid cycle provides the carbon skeletons needed to make iron-scavenging compounds. Metabolism of certain carbon sources generates better carbon and fuel from the citric acid cycle. Iron-starved bacteria favor carbon processing through the citric acid cycle in order to produce more iron-scavenging compounds. Aristilde said this finding is significant because the research reveals that inorganic nutrients can have a direct impact on organic processes.
"The hierarchy in carbon metabolism highlights that selectivity in specific carbon usage is strongly linked to something that is inorganic," Aristilde said. "To put this in the context of climate change, we need to understand what conditions control soil carbon cycling and its contribution to carbon dioxide."
By focusing on the Pseudomonas species in soils, the research group was able to make inferences about other species. The Pseudomonas bacteria also exist as human and plant pathogens, in our gut and elsewhere in the environment. Aristilde hopes that because the bacteria she and her researchers chose to study are so ubiquitous, future research will be able to use her group's findings as a roadmap.
Past research studied organism behavior with a lower resolution of information. While scientists have used genomics to predict what may happen in metabolism of species based on identifying and measuring genes, the Aristilde lab uses metabolomics of the species to capture what is actually happening in metabolism. Their research provides clues that imply many other organisms and systems might also employ similar metabolic strategies.
As an environmental engineer, Aristilde said that her area of study is all about understanding mechanisms and making predictions about how environmental processes like the carbon cycle behave. Beyond carbon cycling and climate change, the study also has implications in plant and human health. Understanding how bacteria that cause inflections change carbon metabolism to compete for iron in their plant or human hosts can enable researchers to better design target treatments.